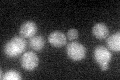
YDR436W

View description
Serine/threonine protein phosphatase Z, isoform of Ppz1p; involved in regulation of potassium transport, which affects osmotic stability, cell cycle progression, and halotolerance
Localization:
Intensity:
Fold change:
Significance:
-
C’ GFP library in SD

cytosol19.22 -
N' NOP1pr-GFP in SD

cytosol154.364 -
N' TEF2pr-mCherry in SD

cytosol33.4563 -
N' NATIVEpr-GFP in SD

punctate17.521 -
N' TEF2pr-VC and Cyto-VN in SD

below threshold26.345 -
C’ GFP library in SD+DTT

cytosol23.241.2No -
C’ GFP library in SD+H2O2
cytosol24.481.27No -
C’ GFP library in Starvation Media

cytosol22.051.14No -
C’ GFP library on the background of Pup2-DaMP

cytosol -
C’ GFP library on the background of CCT mutant

cytosol23.74861.23482No
